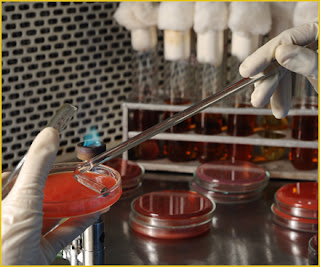

WATER TREATMENT
What
is the basic nature of water?
Water is a complicated and incompletely understood chemical
compound with a number of peculiar characteristics. Fresh formed rain is the
purest form of water. It is also its highest energy form. Considerable energy
is expended by acquisition of solute impurities in passing from rain cloud to
the final water tap.
How
do impurities get into water?
Falling rain
water passing through the air contacts carbon dioxide and sulfur dioxide,
forming carbonic acid and sulphuric acid in weak solution. Upon meeting with
the earth , water encounters lime stone and other minerals to form calcium bicarbonate and sulphate. Calcium carbonate is the most prevalent impurity in
tap water and accounts for most of its hardness.
What other
minerals may be present in tap water?
Sodium
chloride , iron , magnesium, nitrates manganese , copper, zinc, iodide and
fluoride are common ionic constituents. The types of minerals present in the
geographic area and the time the water is in contact with them determine the
content.
Trace elements
present include arsenic, silver, strontium , selenium, chromium , lead,
cadmium, cyanide, barium, tin and others.
Are these
minerals harmful?
Nitrates may
cause methemoglobinemia – a situation in which red cell hemoglobin cannot
transport oxygen. Copper in excess may cause hemolysis , pancreatitis or a type
of hepatitis.
Manganese can
be toxic and iron may possibly be so. Fluoride is believed by many to aggravate
uremic bone disease but this is not proved. It does accumulate in bone and it
is toxic to enzyme system.
Do the trace
elements offered any hazard?
The effect of
these is largely unknown. Tin has been found in significantly higher quantity
in tissues of dialyzes uremic patients than in nonuremic individuals. Aluminum
also accumulates and has been
tentatively related to the dialysis-dementia syndrome. Zinc causes
gastrointestinal upset and may produce anemia,
Are there any
other materials in tap water ?
Nonionic
organic compounds particularly nitrogenous matter such as proteins an
polypeptides , phenols, indoles and aldehydes may be present. Solid aprticles
of iron. Sand and silica are frequent , Suspended material including mud, algae
, plankton, bacteria viruses , pyrogenic matter and dissolved gases ( ammonia ,
carbon dioxide, chlorine ) are often present. The most common soluble organic
compounds are chloramines resulting from urban water treatment systems. The
content of these as well as of ionic impurities varies with the water sources ,
season and distribution system..
Why is
special treatment necessary for water
used to make dialyzing fluid ?
During
hemodialysis the amount of water that contacts the patient’s blood is 20 or
more times the amount taken in by drinking. Water ingested by drinking is
processed by gastrointestinal tract prior in reaching the bloodstream This selective membrane can alter the rate at
which foreign substances are absorbed from ingested water. In a dialyzer system the water in
dialysate is separated from blood by a
non living artificial membrane. The dialyzer membrane can not select ions to be
absorbed or reject and they pass
diffusion. Thus ,substances hat might be harmless in drinking water may be toxic in dialysis water.
What methods
are used to treat water for use in hemodialysis ?
·
Filtration
·
Softening
·
Adsorption by activated
charcoal
·
Deionization
·
Revers Osmosis ( RO )
What is
accomplished by filtration ?
Suspended
particles ( mud, sand, rust, algae ) are removed by mechanical filtration
through a wound filament or membrane cartridge. These effectively filter
particles down to about 5 µin size. Filtration does not remove dissolved
particles or ions from the water.
How is
activated charcoal used in water treatment ?
Activated
charcoal acts by adsorption. It does not remove electrolytes such as sodium or calcium . It has a unique ability
to adsorb chloramines , odor-producing materials and lower molecular weight (
60 to 300 daltons )material s as well higher molecular weight organic matter.
What does
softening of water achieve?
Hardness of
water is produced primarily by calcium and magnesium ions. Commercial softening
units replace these diavalent ions with sodium ions from an exchange resin bed
on a milliequivalent-for-milliequivalent basis. For each calcium ion removed
,two sodium ions are added .
If the water
is very hard, the use of a softener will remove most of the calcium and
magnesium ion prior to further treatment. . If a deionizer is used , the
softener will reduce the divalent ion load presented to the deionizer resin bed
and prolong its life. If the subsequent treatment is by RO the removal of
calcium and magnesium by the softener
may result in higher quality water and longer RO membrane life.
water softener
What problems
occur with use of water softener ?
If raw water
is very hard ,considerable sodium is substituted by the exchange for calcium
and magnesium. Municipal water supplies often vary seasonably or even during a single day if
multiple sources are used. Monitoring of softener function is done by checking
the total ‘Hardness “ of outflow water and is difficult on a continuous
basis.
What is
deionization ?
Ion exchange
resins somewhat like those of a water
softener but most sophisticated, are used to remove both cations and anions
from the processed water.
How does a
deionizing unit work ?
Essential are a cation bed and an anion bed . Each bed is composed of grains of ion
exchange resin about the size of fine sand, called zeolite. Zeolites are large
organic chemical molecules that have active side chain groups attached to
them.. The side chain of the zeolite in
the carbon bed is a carbonyl ( -COOH ) group . In the anion resin bed there are
attached substitute
Ammonium group
( NH3 and OH ). In passage through the cation bed calcium ,magnesium sodium and
other cations in the water combine with the carboxyl radicals with the release
of hydrogen ions. In the anion bed anions – chloride , fluoride , sulphate,
nitrate, bicarbonate and others are
exchanged for the hydroxyl ion (-OH) .
The release hydroxide ion combine with
hydrogen ions released at the cation bed to form water chemically.
CATIONS ANIONS
Na Cl
K F
Ca So4
Mg NO3
CATION
RESIN BED
H Cl
H F
H SO4
H NO3
ANION
BED RESIN
H OH
H2O
Above Schematic diagram of de ionizing apparatus
What is the
difference between two bed and single bed deionizer system ?
The two bed
system has the cation removing and anion removing resins in separate tanks;
water flows through the cation bed and then to the anion bed . The single bed
or mixed bed system system has the two resin mixed together. The single bed
system because of the mixing produces a much higher quality ( pure ) water. It is also more costly.
What are
problems in deionizer-use ?
1. One problem is obtaining the maximum
flow rate needed ( standard units for
center use have a maximum of about 300
gallons per hour )
2. The ionic of raw water presents a
problem - a finite quantity of ions can
be removed by a bed of given size, hence
a lesser volume of water with a high content can be processed
than if the content is low.. The life of the deionizer bed depends on water
composition and / or volume .
3. Beds tend to exhaust suddenly, it is
necessary to have parallel or twin installation so that
a switchover can be made while
the exhaust of tanks are replaced.
4. Sometimes during regeneration of the
resin tanks channel form in the bed. Such a tank may exhaust in an abnormally
short time. Usually the anion and cation resin s exhaust at different .times.
Depending on which exhausts first , their may be an excess of H or of OH ion
in the product water.
What is
reverse osmosis ? (RO)
This is a
process that utilizes semipermeable membrane and pressure to remove both
organic matter and electrolytes from water . The membrane repel ions, Organic
particles are screened out while water passes through the micropores of the
membrane surface by ultrafiltration. These pores are approximate 200 nm in
diameter.
Reverse osmosis
How does the
membrane “repel“ electrolyte ?
This results
from electrochemical tension at the water membrane interface, and increases
with high valence salts. Diavalent ions such as calcium, magnesium are repelled
at a greater distance from the membrane surface than are monovalent ions ( Sodium ). The rejection
rate for divalent ions is greater than 95 % and for monovalent ions 90 to 95 %
. Thus up to 10 % of the ions in the feed water may remains in the final
product ( purified ) water,
How are
organic compounds processed by the membrane ?
Organic
compounds have no net charge and are not electrically repelled but are
physically screened , depending on molecular size & shape, by the mambrane.
Almost all particles of molecular weight greater than 200 daltons are rejected.
This includes bacteria, viruses, and known pyrogens.
OVERHEAD ----------> IRON REMOVER ---------> WATER
SOFTNER ------->
<-------- DE <--------- CHAR COAL <---------- CHLORINATION <-------
CHLORINATION TREATMENT ( 5 ppm
Chroline )
----------------> DEMINERALIZATION ------------> DISTILLATION
Chlorination : 0.5 % Sodium Hypochloride
solution 2 drops / 250 ml